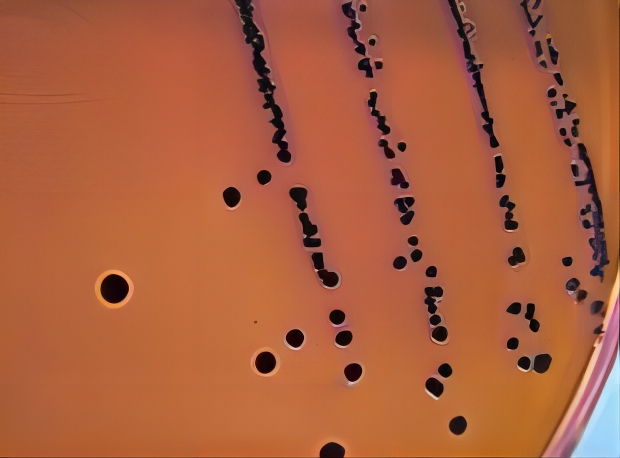
伊红美蓝琼脂 伊红美蓝琼脂
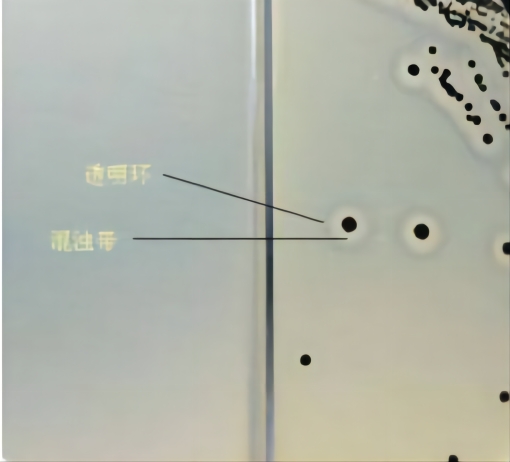
Baird-Parker琼脂 Baird-Parker琼脂
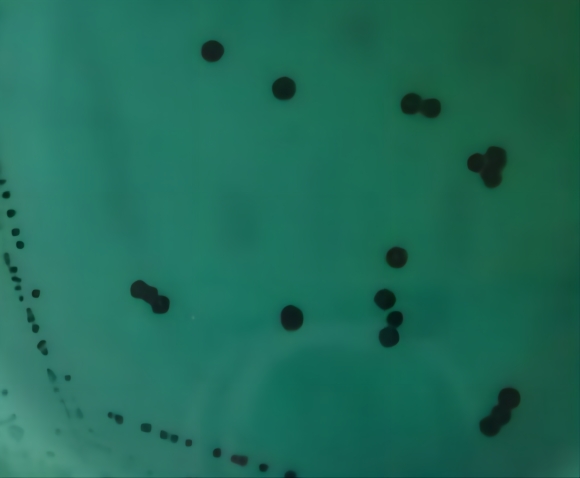
HE琼脂 HE琼脂
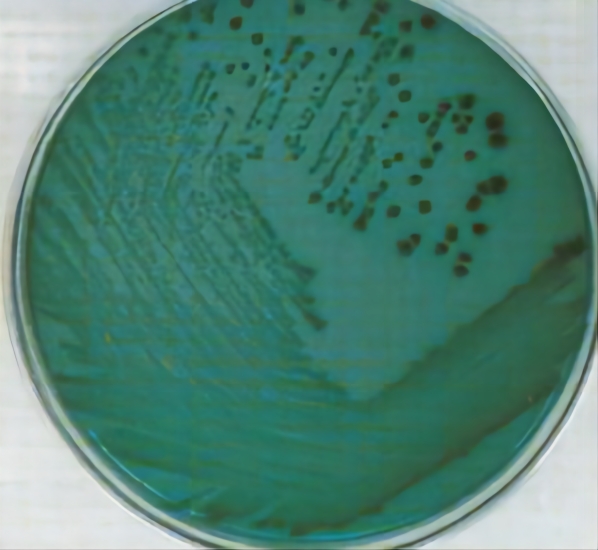
TCBS琼脂 TCBS琼脂

最常用检测致病菌培养基原理介绍!
发布时间:2022-10-12 浏览次数:3458
微生物检测人员天天都在培养和鉴定各种细菌真菌,培养和鉴定过程中肯定都会用到各种各样的培养基,尤其是一些选择性和鉴定性的培养基。我们每天都在用的这些培养基,你知道它们的原理吗?今天小编就挑选几种常用的培养基给大家科普一下。
伊红美蓝琼脂
伊红美蓝琼脂培养基,简称EMB,常用于大肠埃希氏菌的检测,其主要原理是培养基中存在的伊红和美蓝这两种染色剂,其中伊红为酸性染料,美蓝为碱性染料。大肠埃希氏菌在伊红美蓝上的典型状态为具黑色中心有光泽或者无光泽。当大肠埃希氏菌分解乳糖产酸时细菌就会带正电荷被伊红染成红色,再与美蓝结合形成紫黑色菌落并带有金属光泽;不分解乳糖产酸的细菌就不着色,伊红和美蓝就不能结合,因此沙门氏菌等为无色或琥珀色半透明菌落。典型的大肠埃希氏菌在伊红美蓝培养基上如图:
Baird-Parker琼脂
Baird-Parker琼脂主要用于金黄色葡萄球菌的选择性分离培养,其主要原理是培养基中含有的丙酮酸钠、甘氨酸、氯化锂、亚碲酸钾等。金黄色葡萄球菌在Baird-Parker平板上的典型状态为黑色,且周围有一浑浊带,在外侧有一透明环,呈现“双环”现象。其原理为:丙酮酸钠和甘氨酸刺激葡萄球菌的生长,氯化锂和亚碲酸钾抑制非葡萄球菌,含有卵磷脂酶的葡萄球菌降解卵黄是菌落产生透明圈,而脂酶作用产生不透明的沉淀环,凝固酶阳性的葡萄球菌还能还原亚碲酸钾产生黑色菌落。一般应该注意,典型的金黄色葡萄球菌是具有“双环”的,即一浑浊带之外还有一圈透明环,只具有单环浑浊带的一般是变形杆菌。金黄色葡萄球菌在Baird-Parker平板上的典型菌落如图:
HE琼脂
HE琼脂培养基常用于肠道致病菌的检测,比如沙门氏菌的分离性选择就会用到。沙门氏菌在HE琼脂上的典型状态为蓝绿色或蓝色,多数菌落中心黑色或者几乎全黑色;部分菌株为黄色,中心黑色或几乎全黑色。其原理主要是非目标菌会分解乳糖、蔗糖和水杨素产酸,而pH指示剂溴麝香草酚蓝和酸性复红会使产酸菌呈红色,而沙门氏菌等不发酵产酸的菌或呈蓝绿色。同时胆盐、去氧胆酸钠以及两种指示剂可以抑制革兰氏阳性菌,硫代硫酸钠和柠檬酸铁铵会检测硫化氢的产生使菌落中心呈黑色。沙门氏菌在HE琼脂平板上的典型菌落如图:
TCBS琼脂
TCBS琼脂又叫硫代硫酸盐柠檬酸盐胆盐蔗糖琼脂培养基,用于致病性弧菌的选择性分离。例如副溶血性弧菌。典型的副溶血性弧菌在TCBS上呈圆形、半透明、表面光滑的绿色菌落。培养基中的氯化钠可刺激弧菌的生长;蔗糖是可发酵的糖类;胆酸钠、牛胆汁粉、硫代硫酸钠和柠檬酸钠及较高的pH可抑制革兰氏阳性菌和大肠菌群;霍乱弧菌对酸性环境比较敏感,因此该pH值可增强其生长;硫代硫酸钠与柠檬酸铁反应作为检测硫化氢产生的指示剂;溴麝香草酚蓝和麝香草酚蓝是pH指示剂。副溶血性弧菌在TCBS平板上的典型菌落如下图:
以上四种培养基都是我们在检测致病菌中常用的,通过对它们的原理的了解,是不是对您日常的检测工作有所帮助呢?
来源:网络,环凯小编转载于食品微生物检测公众号!
说明:文章、视频、图片等所有内容,仅用于学习交流,若有侵权内容及其他涉法内容,请及时联系删除或修改,特此声明!
